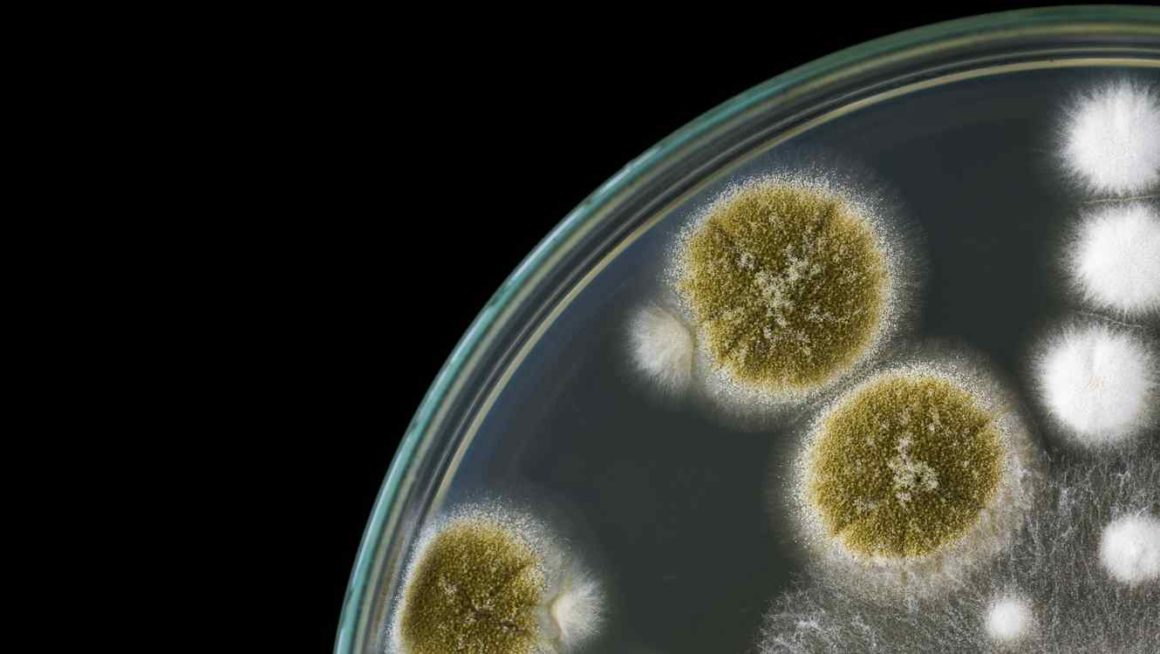

La bacteria come el plástico y lo convierte en agua 🦠➡💧
Actualmente, al año arrojamos más de 300 millones de toneladas al océano. Por lo que la contaminación se ha vuelto un problema realmente grave. La novedad del momento es una bacteria, desarrollada por las estudiantes Miranda Wang y Jeanny Yao, de China, quienes llevan trabajando desde hace unos años atrás y que hoy obtienen los resultados de su éxito, pues han conseguido dos patentes con un financiamiento inicial de 400 mil dólares para comenzar a desarrollar el producto.

¿Cómo funcionan realmente las bacterias que comen plástico?
Estas bacterias funcionan principalmente con PET, secretan una enzima (un tipo de proteína que acelera reacciones químicas) conocida como PETasa, la cual divide varios enlaces químicos del plástico y deja moléculas más pequeñas que las bacterias pueden absorber, de manera tal, que usan el carbono que hay en ellas como fuente de alimento.

Parece que esta nueva enzima evolucionó específicamente para dicha tarea. Esto indica que podría ser más rápida y eficiente que otras, de las cuales se tenía conocimiento anteriormente, por lo que sería posible utilizarla en el bio-reciclaje.
Sin embargo, para la cantidad de plástico total de los océanos, no es una solución mediata. Pero con el próximo desarrollo y evolución del proyecto, podría convertirse en gran potencial pues, además, estas pequeñas bacterias son capaces de convertir plástico en CO2 y agua.
La tecnología de éstas, se emplea de dos maneras: para limpiar las playas y océanos, o también para producir materias primas para elaborar prendas de vestir.

Desarrollo de las bacterias
El desarrollo de las bacterias se da en dos partes. En primer lugar, el plástico es disuelto y las enzimas lo catalizan con lo que el plástico se transforma en fracciones sumamente maleables. Asimismo, estos componentes se colocan en una estación biodigestora, donde se compostan como si fuesen restos de comida.
El proceso dura tan solo 24 horas, para pasar de plástico a agua, ¡sumamente rápido!